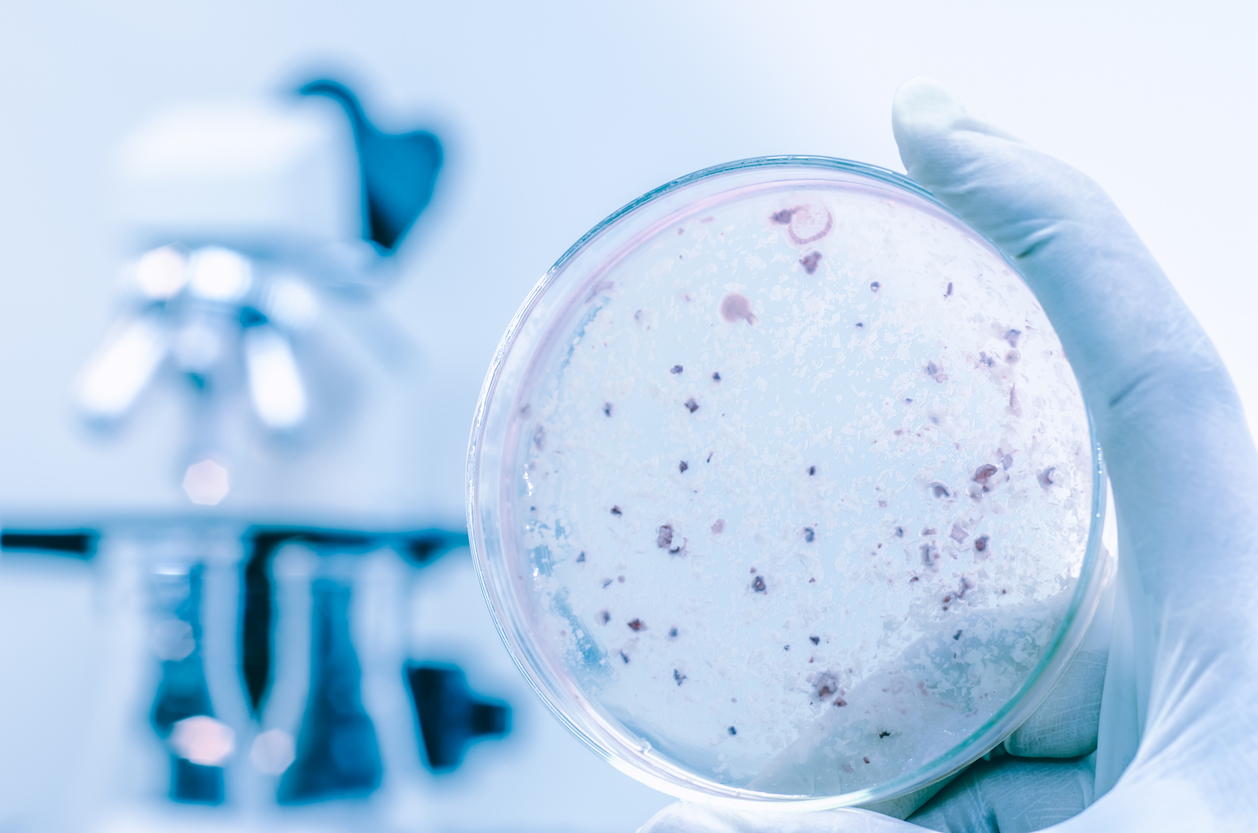

108 κρούσματα με 5 νεκρούς στη Νέα Υόρκη
Βρέθηκαν μολυσμένοι 12 πύργοι ψύξης μεγάλων κτηρίων. Ένα από αυτά είναι το Νοσοκομείο του Χάρλεμ.
Δεκάδες κρούσματα έχει προκαλέσει η νόσος των λεγεωναρίων στο Χάρλεμ της Νέας Υόρκης, όπου βρέθηκαν μολυσμένοι με το υπαίτιο βακτήριο 12 πύργοι ψύξης μεγάλων κτηρίων. Μεταξύ αυτών συμπεριλαμβάνεται το Νοσοκομείο του Χάρλεμ.
Τα δύο πρώτα κρούσματα αναφέρθηκαν στις 22 Ιουλίου. Έως και χθες (18/08/2025), όμως, είχαν ανέλθει σε 108, με πέντε από τους ασθενείς να χάνουν τη ζωή τους. Από τους ανθρώπους που νόσησαν, οι 14 εξακολουθούν να νοσηλεύονται στα νοσοκομεία, ανακοίνωσε το Υπουργείο Υγείας της Πόλης της Νέας Υόρκης (NYC).
Ο θάνατος του πέμπτου ασθενούς ανακοινώθηκε χθες. Είχε όμως συμβεί αρκετές ημέρες νωρίτερα. Οι Αρχές όμως τον ανακοίνωσαν μόνον όταν επιβεβαίωσαν πως σχετίζεται με την παρούσα έξαρση των κρουσμάτων.
Η νόσος των λεγεωναρίων είναι μία μορφή πνευμονίας. Προκαλείται από το βακτήριο λεγεωνέλλα , το οποίο αναπτύσσεται στο ζεστό νερό. Η νόσος προκαλεί συμπτώματα παρόμοια με αυτά της γρίπης. Μεταδίδεται με την εισπνοή ατμών που περιέχουν το βακτήριο.
Η νόσος των λεγεωναρίων μπορεί να προκαλέσει επιπλοκές, οι οποίες ενδέχεται να απειλήσουν τη ζωή. Αυξημένο κίνδυνο να την εκδηλώσουν διατρέχουν:
- Τα άτομα ηλικίας άνω των 50 ετών
- Οι καπνιστές
- Οι πάσχοντες από νοσήματα των πνευμόνων
- Όσοι έχουν εξασθενημένο ανοσοποιητικό
- Όσοι λαμβάνουν ανοσοκατασταλτικά φάρμακα
Η νόσος των λεγεωναρίων δεν μεταδίδεται από άτομο σε άτομο, ούτε με την κατανάλωση μολυσμένου νερού. Δεν μεταδίδεται επίσης με τον κρύο αέρα των κλιματιστικών. Όταν παρατηρείται συρροή κρουσμάτων, όπως αυτή στη Νέα Υόρκη, οι κυριότερες πηγές του βακτηρίου είναι:
- Οι πύργοι ψύξης
- Τα υδρομασάζ
- Τα σιντριβάνια που ψεκάζουν νερό
Ολοκληρώθηκε η απολύμανση
Τα 12 κτήρια που εμπλέκονται στην έξαρση της Νέας Υόρκης ανακοινώθηκαν μόλις την περασμένη εβδομάδα. Ήδη οι πύργοι ψύξης τους έχουν καθαριστεί και απολυμανθεί. Οι πύργοι αυτοί είναι συσκευές βιομηχανικής ή εμπορικής χρήσης που απορρίπτουν τη θερμότητα από ένα κτήριο, διοχετεύοντάς την στο περιβάλλον μέσω της εξάτμισης του νερού.
Ο αριθμός των νέων κρουσμάτων της νόσου έχει αρχίσει να δείχνει πτωτικές τάσεις, γεγονός που σημαίνει ότι η πηγή του βακτηρίου έχει καταπολεμηθεί. Ωστόσο συγγενείς των θυμάτων ετοιμάζουν αγωγές εναντίον της κατασκευαστικής εταιρείας που εκτιμάται ότι ευθύνεται για την παρούσα έξαρση της νόσου.
Φωτογραφία: iStock








